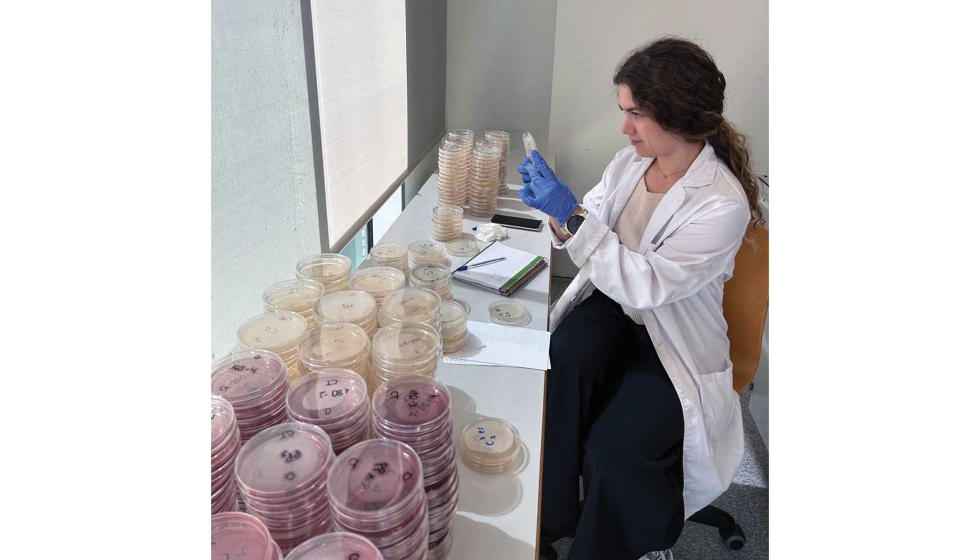
El proyecto ha creado envases a partir de la paja del arroz, los raspones y orujos de la uva y residuos de la elaboraci�n de horchata...

Varbiopac: del residuo agrícola al envasado sostenible que alarga la vida útil de los alimentos
El proyecto Varbiopac, liderado por la Universitat Politècnica de València, transforma residuos como la paja del arroz, los restos de horchata o los orujos del vino en materiales biodegradables con propiedades antimicrobianas y antioxidantes. Una solución innovadora que impulsa la economía circular en el sector agroalimentario y responde a la creciente demanda de envases sostenibles y eficientes.
Raspones y orujos que quedan después del proceso de elaboración del vino, restos de chufa una vez se ha preparado la horchata y otros residuos de difícil reciclaje como la paja del arroz tienen una segunda vida a través de la transformación en materiales biodegradables. De residuo de difícil gestión a oportunidad para una industria como la agroalimentaria que necesita cada vez más envases sostenibles y menos contaminantes, así como un impulso para la economía circular y la valorización de subproductos agrícolas.
Esto es lo que ha buscado el proyecto Varbiopac (Valorización de residuos agroalimentarios en la obtención de materiales biodegradables para el envasado activo de alimentos), desarrollado por personal investigador de la Universitat Politècnica de València (UPV). Han desarrollado unos envases que, además, cuentan con propiedades antimicrobianas y antioxidantes capaces de mejorar la conservación de alimentos y, como consecuencia, reducir el desperdicio alimentario.
Sostenibilidad y oportunidad económica
La sostenibilidad ya no es una opción, es una necesidad. Autoridades y consumidores demandan soluciones más responsables con el medioambiente, y la industria responde desarrollando envases más sostenibles, explica Amparo Chiralt, responsable del proyecto y catedrática de la UPV quien destaca que la sostenibilidad tiene también un impacto económico porque permite minimizar costes asociados a tasas e impuestos que gravan el uso de plásticos convencionales.
Chiralt destaca también que la valorización de residuos agroalimentarios representa una oportunidad económica significativa al convertirlos en nuevos productos comerciales. En lugar de gestionar residuos difíciles y costosos, las empresas pueden generar beneficios adicionales y mejorar su competitividad, incide Chiralt.
El proyecto Varbiopac ha obtenido biopolímeros como almidón o PHBV a partir del residuo de la horchata o la paja del arroz, entre otros residuos locales, así como extractos ricos en compuestos fenólicos con propiedades antimicrobianas y antioxidantes. También han elaborado siete tipos de films activos de envasado de alimentos utilizando extractos y materiales de refuerzo obtenidos de diferentes residuos agroalimentarios.

Respetuoso con el medio ambiente
Para la obtención de los extractos, el equipo de investigadores de la UPV ha empleado técnicas respetuosas con el medio ambiente, como la extracción con agua subcrítica, un proceso que utiliza agua a alta temperatura y presión para actuar como disolvente eficaz sin recurrir a compuestos químicos contaminantes.
El proyecto tiene una aplicación directa en el envasado de alimentos, con ensayos realizados con aceite, carne de cerdo y salmón. Estos materiales presentan un gran potencial para el envasado de alimentos perecederos y también para productos cosméticos.
El proyecto Varbiopac ha recibido financiación del programa Prometeo de la Generalitat Valenciana para grupos de investigación de excelencia y, desde 2022, está trabajando en este objetivo.











































